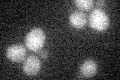
YOR266W
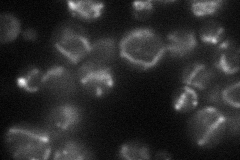
YOR266W
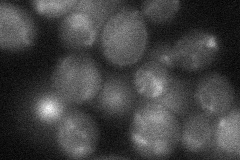
YOR266W
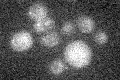
YOR266W

View description
Mitochondrial integral inner membrane protein involved in membrane insertion of C-terminus of Cox2p, interacts genetically and physically with Cox18p; deletion mutant sensitive to the anti-Pneumocystis carinii drug pentamidine
Localization:
Intensity:
Fold change:
Significance:
-
C’ GFP library in SD
below threshold14.78 -
N' NOP1pr-GFP in SD
mitochondria41.9125 -
N' TEF2pr-mCherry in SD

mitochondria313.654 -
N' NATIVEpr-GFP in SD

below threshold16.8482 -
N' TEF2pr-VC and Cyto-VN in SD
mitochondria26.3642 -
C’ GFP library in SD+DTT

cytosol14.560.98No -
C’ GFP library in SD+H2O2

cytosol13.530.91No -
C’ GFP library in Starvation Media
cytosol14.320.96No -
C’ GFP library on the background of Pup2-DaMP

below threshold -
C’ GFP library on the background of CCT mutant

below threshold15.25711.03156No
